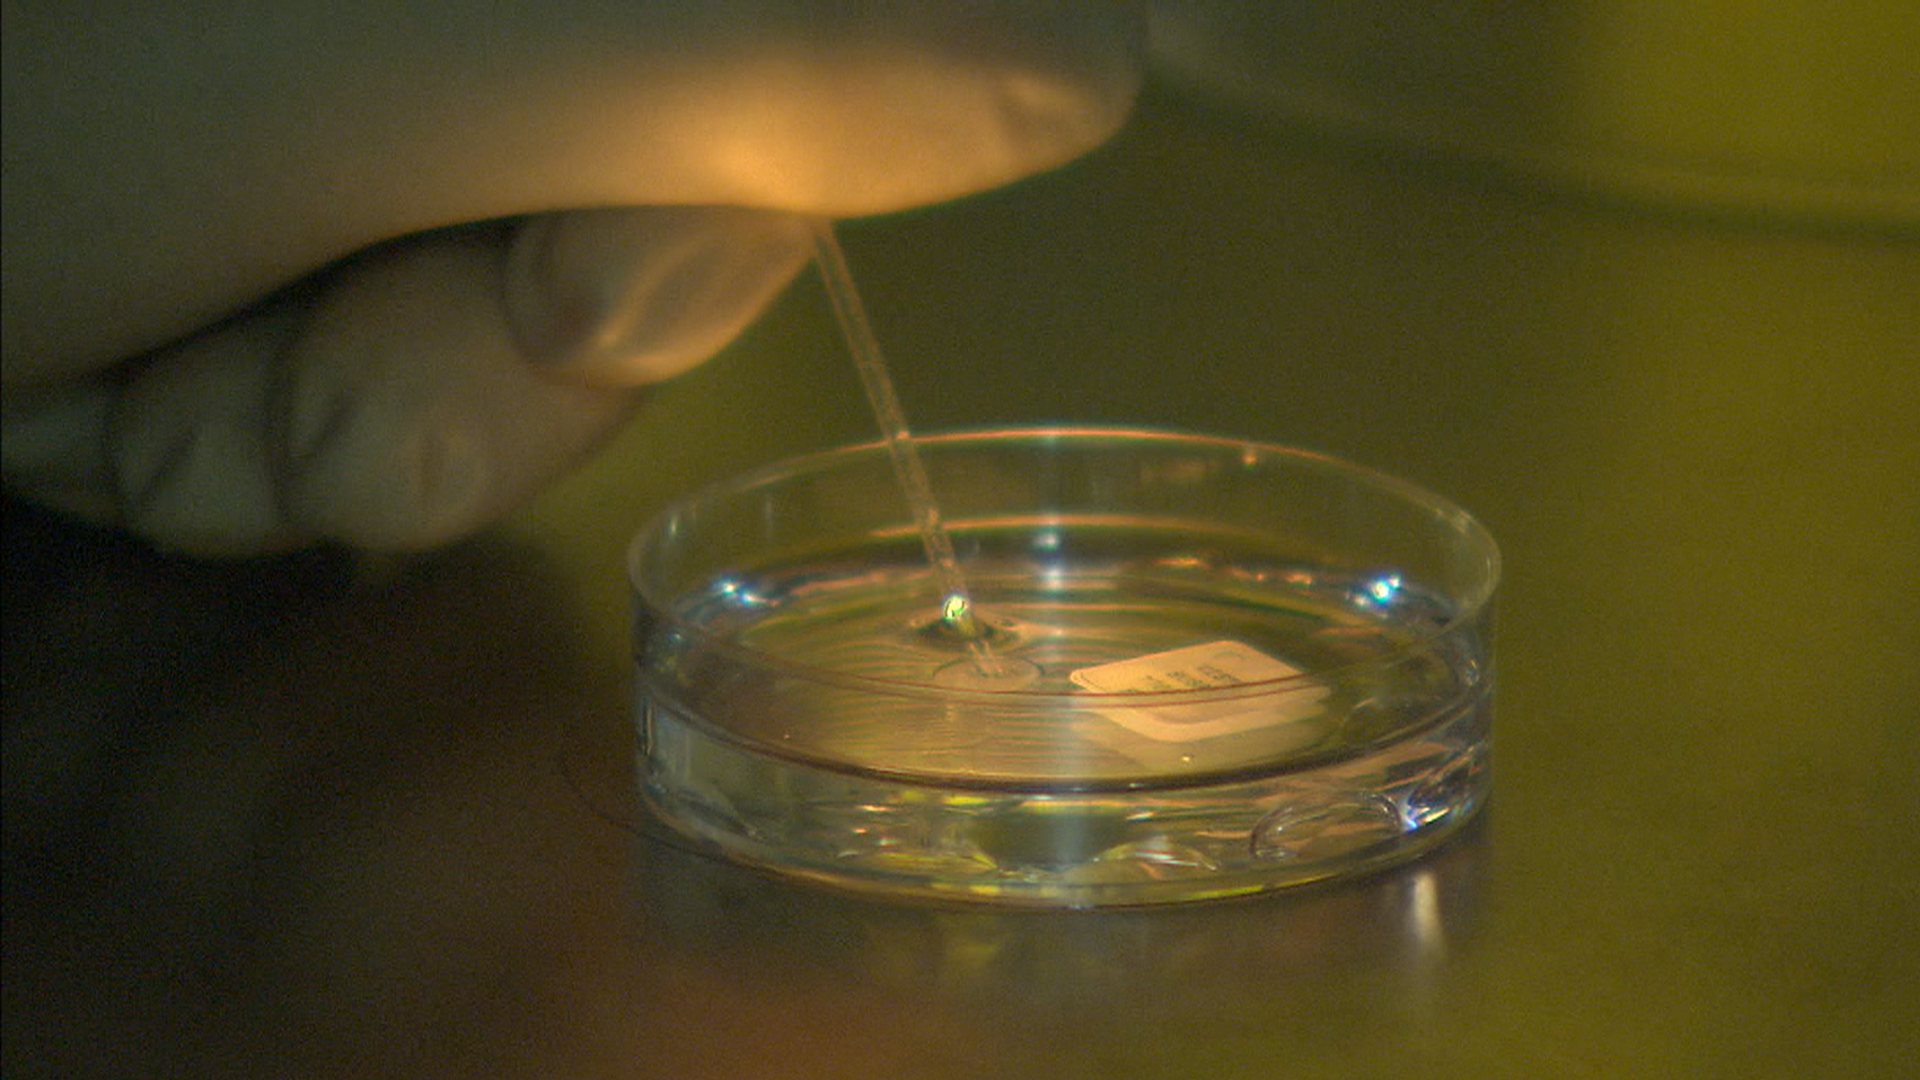

Bank sperm toronto
Bank sperm toronto 111 photos
Sex Tube Clips
Horny College Babes
Teasingshow next repair camshow
Reddit Nsfw Asians
Casting Teens Ass
nimfoboobs dilettante clip on 1/25/15 02:30 from chaturbate
Wiffe Gives Awesome Blowjob & Lets Me Cum On Her Face
Overwatch Sex Manga
Mujeres Masajistas En Houston
Amatsuka innocent fucked delinquents best adult free pic
Mother I'd Like To Fuck pov reverse riding
Shadow large dark ding-dong fucking in hotel
Kayla Green Squirt
Finish pmv
ExploitedCollegeGirls: Vicky
Jungle Girl Vore
Teerfotze vom Handwerker abgefickt
Girl Sucking Cock Porn
Asian girl gangbanged
White Slut Wife Vacation